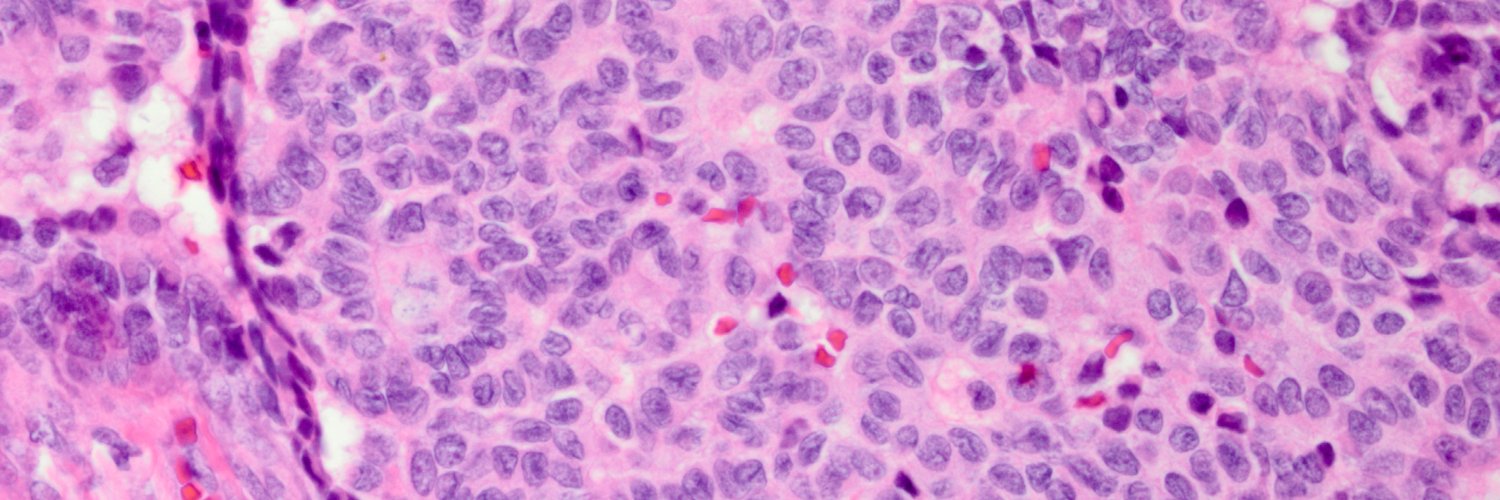
Paul N.Staats, MD banner

Paul N.Staats, MD retweetledi

Just published in @DiagnosticCyto, an Educational Forum piece on the #CytoPath Fellowship Match: doi.org/10.1002/dc.253… @VandaTorousMD @TheABPath @apcprods @cytopathology @PaulStaatsPath @SMonaco3 @aakasharmand @barkanga @NayarRitu #PathTwitter @mtsiddi @PathPro @marthabpitman
English